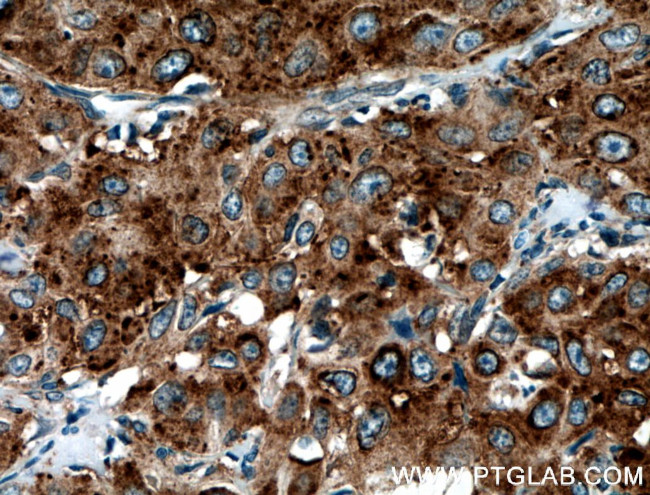
SEPT6 Antibody in Immunohistochemistry (Paraffin) (IHC (P))
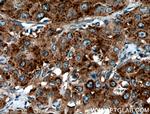
SEPT6 Antibody in Immunohistochemistry (Paraffin) (IHC (P))

Search
Proteintech
SEPT6 Polyclonal Antibody
{{$productOrderCtrl.translations['antibody.pdp.commerceCard.promotion.promotions']}}
{{$productOrderCtrl.translations['antibody.pdp.commerceCard.promotion.viewpromo']}}
{{$productOrderCtrl.translations['antibody.pdp.commerceCard.promotion.promocode']}}: {{promo.promoCode}} {{promo.promoTitle}} {{promo.promoDescription}}. {{$productOrderCtrl.translations['antibody.pdp.commerceCard.promotion.learnmore']}}
产品信息
12805-1-AP
种属反应
已发表种属
宿主/亚型
分类
类型
抗原
偶联物
形式
浓度
规格
纯化类型
保存液
内含物
保存条件
运输条件
产品详细信息
Immunogen sequence: YDLQESNVR LKLTIVSTVG FGDQINKEDS YKPIVEFIDA QFEAYLQEEL KIRRVLHTYH DSRIHVCLYF IAPTGHSLKS LDLVTMKKLD SKVNIIPIIA KADAISKSEL TKFKIKITSE LVSNGVQIYQ FPTDDESVAE INGTMNAHLP FAVIGSTEEL KIGNKMMRAR QYPWGTVQVE NEAHCDFVKL REMLIRVNME DLREQTHTRH YELYRRCKLE EMGFKDTDPD SKPFSLQETY EAKRNEFLGE LQKKEEEMRQ MFVQRVKEKE AELKEAEKEL HEKFDRLKKL HQDEKKKLED KKKSLDDEVN AFKQRKTAAE LLQSQGSQAG GSQTLKRDKE KKNNPWLCTE (86-434 aa encoded by BC036240)
靶标信息
SEPT6 is a member of the septin family of GTPases. Members of this family are required for cytokinesis. This gene is a member of the septin family of GTPases. Members of this family are required for cytokinesis. One version of pediatric acute myeloid leukemia is the result of a reciprocal translocation between chromosomes 11 and X, with the breakpoint associated with the genes encoding the mixed-lineage leukemia and septin 2 proteins. This gene encodes four transcript variants encoding three distinct isoforms. An additional transcript variant has been identified, but its biological validity has not been determined.
仅用于科研。不用于诊断过程。未经明确授权不得转售。
生物信息学
蛋白别名: 2-Sep; 6-Sep; KIAA0128; MGC16619; MGC20339; RP5-876A24.2; septin 2; Septin-6; transcript variant VI; unnamed protein product
基因别名: 2810035H17Rik; C920001C06Rik; KIAA0128; mKIAA0128; SEP2; Sep6; SEPT2; SEPT6; Septin-6; SEPTIN6
UniProt ID: (Human) Q14141, (Mouse) Q9R1T4
Entrez Gene ID: (Human) 23157, (Mouse) 56526, (Rat) 691335